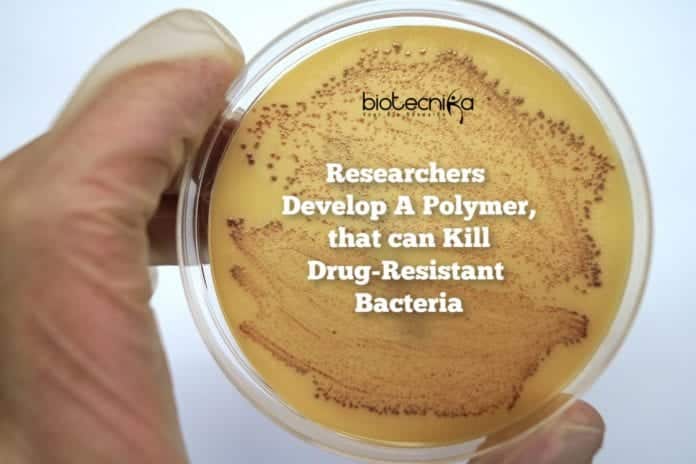

Polymer Kills Resistant Bacteria – New Polymer designed by Researchers
The scientists from SMART and NTA have taken a step towards solving the antimicrobial resistance crisis by designing a polymer that can kill drug-resistant bacteria.
This is a breakthrough that can save many lives as this polymer can pave way for developing drugs to which the bacteria are significantly less resistant
- Bacteria like MRSA, which is resistant to antibiotics used commonly can be killed by the new co-beta-peptide polymer.
- The polymer also works in persistent bacteria and combating biofilm which current antibiotics don’t work well against
- The polymer can be utilized beyond human use, like in swine farming where it is expected to be transformative as MRSA affects almost up to 50% of herds in some regions.
A new antimicrobial polymer that can kill bacteria resistant to the antibiotics commonly used, was designed by the scientists at Singapore-MIT Alliance for Research and Technology (SMART), MIT’s research enterprise in Singapore, and Nanyang Technological University (NTU). This polymer can kill resistant bacteria including the MRSA (Methicillin-resistant Staphylococcus aureus) superbug. Hundreds of thousands of deaths occurring each year due to the drug-resistant bacteria can be prevented by this breakthrough invention as it can pave way for the development of better medicines to which the bacteria are less resistant to.
A paper titled “Enantiomeric glycosylated cationic block co-beta-peptides eradicate Staphylococcus aureus biofilms and antibiotic-tolerant persisters” has all the details explained about the new polymer. A group of researchers at AMR and NTU, lead by the SMART AMR Principal Investigator and Professor at NTU’s School of Chemical and Biomedical Engineering, Dr. Mary Chan-Park, along with the Associate Professor at the Lee Kong Chian School of Medicine at NTU, Dr. Kevin Pethe. A part of SMART, MIT’s research enterprise in Singapore is the Antimicrobial Resistance Interdisciplinary Research Group, (AMR IRG). The Campus for Research Excellence and Technological Enterprise (CREATE) and the National Research Foundation of Singapore (NRF) funds SMART to identify and conduct research on critical problems of societal significance.
According to a recent report by the World Health Organisation, a cause for serious concern with at least 700,000 deaths each year caused by drug-resistant infections and diseases is the increasing resistance to antimicrobial medicines. Deaths related to antibiotic-resistant infection occur every 15 minutes and infection is acquired every 11 seconds in the United States alone. To treat resistant bacteria such as MRSA, alpha-peptides have long been used but they tend to be rather toxic or unstable in the body. The SMART and NTU scientists, for the first time, tested the use of beta-peptides to fight such bacteria in living beings. The new polymer has little to no toxicity impact and it has been designed for stability and it has more time to work in the body as it degrades slowly.
Chan-Park said, ” On many forms of bacteria like persistent bacteria and biofilm, antibiotics usually do not work as they become resistant. Therefore, we are really excited that our new beta-peptide polymer has the potential to combat the existing antibiotic-resistant strains of bacteria. Further, it has shown its benefit over the antibiotics currently in use, as they have limited action upon biofilm and persistent types of bacteria but the polymer has proven its lethality against them.”
In preventing the staggering number of deaths from persistent and resistant bacteria, new innovative medical research like the new co-beta-peptide is a crucial step. To cure the livestock affected by MRSA, AMR plans to test the use of this polymer here as this is a growing issue globally, with around 50% of pig herds affected by the virus in parts of Europe. The virus has been detected in 20-80% of workers in MRSA-positive herds and the new drug will be particularly beneficial to farmworkers.
Testing the polymer on animals infected by MRSA in pig farms is the next step for the research. For the usage of the drugs by the public, the researchers are preparing to have the drugs tested in clinical trials.
Pethe said, ” To combat antimicrobial resistance that hasn’t been done before, this is a promising new approach. It shows low toxicity and good potency and thus it can be on the drug development pathway and we are looking forward to having this developed for humans as a topical drug.”
For further development of the antimicrobial polymers, particularly for human use, AMR is looking for potential partners currently.
The science journal Nature Communications published this paper.
Author: Prathibha